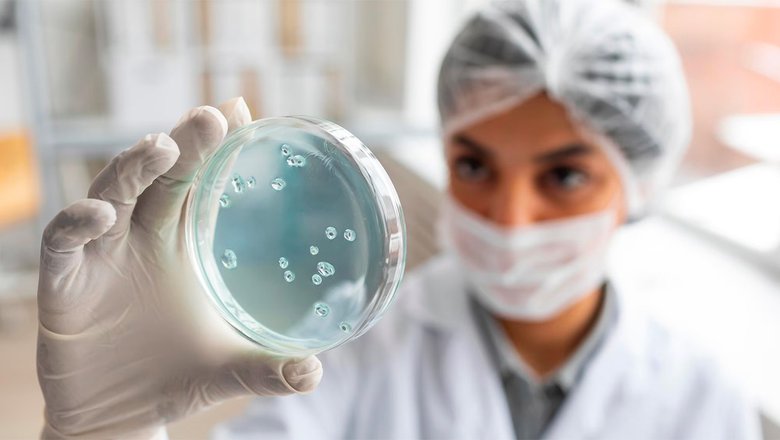
Како бактерије у нашим цревима обликују цело тело

Црева нису само пасивни део нашег организма — она активно утичу на имунитет, метаболизам и […]
Како тело упозорава да је време да бринемо о цревима
Наше тело ретко шаље сигнале без разлога. Надутост, гасови, затвор, пролив, умор након јела или […]
Зашто се осећамо боље када црева раде како треба
Истраживања све више потврђују да црева и мозак не функционишу одвојено. Напротив, међу њима постоји […]
Шта стварно хранимо када једемо — тајна утицаја хране на црева
Свакодневни избори на тањиру директно утичу на то како се осећамо. Црева нису само цев […]
Како бактерије у нашим цревима обликују цело тело
Микробиом — збирка микроорганизама који настањују наша црева — у последњих неколико година постао је […]